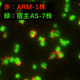

研究成果(プレスリリース)2022

2022年12月27日
親しき仲にも礼儀あり
2022年12月27日
細胞一つずつの“顔つき”から“調子”を見抜く
2022年12月21日
鉄シリコン化合物における室温下の電流誘起磁化反転の実現
2022年12月20日
インスリン受容体の遺伝子疾患モデルの確立
2022年12月20日
生薬「甘草」の染色体スケールのゲノム解読に成功
2022年12月19日
脂質の二重結合位置を見極める新たな構造解析手法の開発
2022年12月15日
抗体を作り続ける長寿命細胞を発見
2022年12月15日
レントゲン1枚から「X線年齢」を算出
2022年12月15日
新原理グラフェントランジスタによる高速・高感度テラヘルツ波の検出に成功
2022年12月14日
JWSTが捉えた原始星を取り巻く氷の分子
2022年12月14日
冠動脈疾患の遺伝的リスクを体系的に解明
2022年12月14日
免疫抑制剤の新しい作用メカニズムの解明
2022年12月14日
微生物の薬剤耐性進化を大規模データから予測
2022年12月13日
小胞体での脂質のグルコース化反応は低酸素ストレスによる細胞死を抑制する
2022年12月12日
DNA複製と細胞運命決定をつなぐもの
2022年12月7日
電子が質量を失って液晶になる物質を発見
2022年12月7日
膜ポンプによる膜輸送機構の普遍的概念の提唱

2022年12月5日
植物が根から鉄を吸収する機構の解明
2022年12月1日
極低温の量子流体中に現れる普遍的な力
2022年12月1日
胆道がんの「ゲノム医療」に貢献
2022年12月1日
物理と深層学習による地殻変動解析
2022年12月1日
日本人集団の腸内細菌叢・ウイルス叢の特徴を解明
2022年11月30日
染色体の中で折りたたまれたDNAから遺伝情報を読み取る仕組みを解明!
2022年11月29日
電解水素水の日常的継続飲用者は、酸化ストレスが低く、腎機能指標が良好。
2022年11月28日
300万気圧を超える圧力下で金属鉄の音速測定に成功
2022年11月28日
皮膚上および体内埋め込み型センサー用の極薄伸縮性導体
2022年11月25日
卵子形成に必須なタンパク質DPPA3によるUHRF1の機能阻害の分子機構を解明
2022年11月25日
電気的な偏りのない層状結晶に歪みを加えて面内に電荷の偏りと光起電力効果を実現
2022年11月25日
マグネターは超強磁場を持つ大気のない中性子星
2022年11月25日
ブラックホールからX線の偏光を初観測
2022年11月24日
極低温氷表面でのOHラジカルの動きやすさを初めて測定
2022年11月22日
カーボンナノチューブの近赤外発光の波長制御・高機能化技術を開発
2022年11月22日
加齢黄斑変性の発症に関わる2つの新規感受性領域を同定
2022年11月22日
非翻訳RNAの発現を予測するAIの開発
2022年11月21日
寛容な子育てに必要な脳
2022年11月21日
アトピー性皮膚炎の発症年齢の遺伝基盤
2022年11月17日
超中性子過剰同位元素ナトリウム-39を発見
2022年11月17日
難治性前立腺がんをアルファ線で攻撃
2022年11月17日
細胞のマイクロ環境を操作
2022年11月16日
〝酵母〟なのか〝キノコ〟なのか
2022年11月15日
関節リウマチにおけるリウマチ因子サブタイプと遺伝因子
2022年11月14日
安全な心臓血管手術のための人工冬眠の可能性
2022年11月11日
遺伝的がんリスク体質の人は若くしてがんになりやすい
2022年11月11日
全ゲノム解析による慢性リンパ性白血病患者の層別化に成功
2022年11月10日
国際ゲノム解析により関節リウマチの遺伝的背景を解明
2022年11月9日
様々な元素の分布を可視化する「放射化イメージング」に成功
2022年11月4日
肝臓がんの分子分類と治療薬選択
2022年11月2日
ヒトの複雑な形質に対する希少なコピー数多型の影響
2022年10月31日
量子光のパルス波形を自在に制御する手法を開発
2022年10月28日
スペルミジンはT細胞の脂肪酸酸化を直接活性化し老化による抗腫瘍免疫の低下を回復させる
2022年10月28日
二次代謝物シデロフォアによる分裂酵母の適応生育と一次代謝への影響
2022年10月27日
食べ過ぎを防ぐ脳の仕組み
2022年10月27日
新型コロナウイルス世界最速検出装置の小型化・低コスト化
2022年10月27日
クォーク物質を重力波で探る
2022年10月26日
電解水素水の日常的飲用は、炎症性腸疾患モデルラットの腸組織の炎症を抑えることで腹部疼痛を緩和する
2022年10月26日
加硫天然ゴム中の未知構造が明らかに
2022年10月25日
世界一コンパクトな超1GHzのNMR装置の開発に成功
2022年10月25日
全固体電池内のリチウムイオンの動きを捉えることに成功
2022年10月25日
植物が切断されても、傷口を修復してつなげる仕組みを解明
2022年10月21日
天然記念物ヒブナの起源を解明
2022年10月21日
心臓の異常を光で診断
2022年10月20日
圧力駆動型ガラス発電機
2022年10月19日
加速器実験によるr過程の同位体比の再現に成功
2022年10月18日
1細胞ゲノム解析用マイクロカプセル
2022年10月18日
一つの植物細胞を丸ごと3次元で再現
2022年10月17日
幾千のAIで複雑な生態系を読み解く
2022年10月13日
植物脂質合成の鍵となる酵素の機能を解明
2022年10月13日
大規模ゲノム情報を活用して治療薬候補を探索するゲノム創薬の枠組みを提案
2022年10月13日
世界最大規模のゲノム解析で身長の遺伝的背景を解明
2022年10月13日
クモ糸の構造と力学物性をデータベース化
2022年10月12日
炭素繊維複合材の接着接合領域の化学結合分布を可視化
2022年10月12日
離れたシリコン量子ビット間の量子接続に成功
2022年10月11日
ヒト腸内細菌と代謝物質を介した免疫応答が新型コロナウイルス感染症および合併症に与える影響を発見
2022年10月6日
巨大量子系シミュレーション用の量子回路設計法を構築
2022年10月5日
植物進化の解明と微細藻類の高度な産業利用の促進
2022年10月5日
睡眠に関わるたんぱく質リン酸化酵素の働きを解明
2022年10月4日
無細胞タンパク質合成を用いた迅速なタンパク質結晶の合成
2022年10月1日
スキルミオン人工知能素子
2022年9月30日
細胞小器官を接着する新技術「オルガネラグルー」を開発
2022年9月30日
世界初 雷雲のガンマ線イメージングに成功
2022年9月29日
植物毒の「現地合成」でがん細胞の増殖阻害に成功
2022年9月28日
巨大Y染色体発見から99年目の快挙
2022年9月27日
日本人集団に特徴的な同類交配の遺伝的影響を発見
2022年9月26日
自己修復性を示すポリイソプレンの開発に成功
2022年9月24日
人工アジュバントベクター細胞投与による免疫の活性化
2022年9月21日
新しい核偏極リレー法により「水の高核偏極化」に成功
2022年9月21日
患者由来iPS細胞の肝臓難病モデル
2022年9月16日
二次元金属に「フェロバレー強磁性」を誘起することに成功
2022年9月15日
トリプシンを分解する腸内細菌の同定に成功
2022年9月15日
励起一重項と三重項のエネルギー逆転を実現
2022年9月14日
分子サイズの世界を明るく照らす超高強度X線集光ビームをX線フラッシュ顕微鏡に応用
2022年9月14日
赤ちゃんの泣きやみと寝かしつけの科学
2022年9月13日
素子間の結合による超伝導電流の非局所制御に成功
2022年9月13日
筋萎縮性側索硬化症(ALS)の発症機構の一端を解明
2022年9月13日
窒素化合物の選択的化学変換
2022年9月9日
分子モーターキネシンが細胞の突起の長さを調節するしくみを解明
2022年9月9日
ゲノム編集で遊泳不全ミドリムシの作出に成功
2022年9月6日
悪性リンパ腫の大規模ゲノム解析
2022年9月6日
大腸がんの「ゲノム医療」に貢献
2022年9月5日
再充電可能なサイボーグ昆虫
2022年9月5日
硫黄の化学状態を50ナノメートルの高分解能で捉える計測技術を確立
2022年8月30日
非平衡フォノン環境が生み出すスピンダイナミクス
2022年8月30日
国産ゲノム編集技術CRISPR-Cas3が二本鎖DNAを切断する仕組みを解明
2022年8月26日
東アジアに多い小児脳腫瘍「頭蓋内胚細胞腫瘍」の発症に関わる遺伝子の発見
2022年8月25日
細胞膜の中ではたらく特殊なタンパク質分解酵素の構造を解明
2022年8月25日
エタノールが植物の乾燥耐性を高めることを発見
2022年8月25日
シリコン量子ビットで量子誤り訂正を実現
2022年8月24日
新型コロナウイルス感染者の隔離短縮は可能か?
2022年8月23日
全身性エリテマトーデスの病態解明へ
2022年8月22日
アーキアに寄生するナノアーキア
2022年8月19日
惑星の形成現場に冷たい陰
2022年8月19日
遺伝子の発現とクロマチン構造の維持を両立させる仕組み
2022年8月18日
寄生植物が宿主に接近するメカニズムの解明
2022年8月18日
ES/iPS細胞からのヒト臓器の間充織細胞作製法
2022年8月10日
電気を使った海産ミミズの観察と制御
2022年8月9日
ゲノムとAIにより食道がんの術前化学療法の効果を予測
2022年8月5日
植物の精子形成に関わる新規因子を発見
2022年8月4日
分化細胞からの植物体再生
2022年8月2日
新型コロナウイルス変異株の抗体量を8分で自動定量
2022年8月2日
世紀を超えたDNA空間配置の謎を解明
2022年8月1日
新たな植物の硫黄分配メカニズムを発見
2022年7月27日
太古の地球における酸素の起源
2022年7月26日
タンパク質欠乏をしのぐ栄養適応の新機構
2022年7月26日
体細胞における反復配列間の組換えを解析
2022年7月22日
オキシトシン神経細胞の脈動を捉える
2022年7月21日
反強磁性体における垂直2値状態の電流制御に成功
2022年7月21日
ネムリユスリカ幼虫を用いた生存圏探索デバイス
2022年7月20日
広帯域高周波アンプを用いた高速パルサーの開発に成功
2022年7月15日
溶液中ナノ粒子を3次元観察できるデータ処理手法
2022年7月15日
高強度レーザー照射による物質表面の超高速構造変化をナノスケールで観測
2022年7月14日
細胞の力覚異常が単眼症を引き起こす
2022年7月12日
高精度ミラーと計算を組み合わせた軟X線顕微鏡を開発
2022年7月7日
ゲノム編集のための昆虫遺伝子機能アノテーションワークフローを開発
2022年7月1日
市販のLED照明をX線放射線環境下で使用可能に
2022年6月28日
CAMSAP2タンパク質による中心体に依存しない微小管ネットワーク形成のしくみを解明
2022年6月28日
再生医療用細胞レシピをロボットとAIが自律的に試行錯誤
2022年6月28日
1細胞遺伝子発現解析用サンプル多重化のための新技術
2022年6月28日
病原菌はヘムを解毒して血中で増殖する
2022年6月27日
インシュリン・糖代謝による動物の日常行動の制御
2022年6月27日
自己免疫疾患とアレルギー疾患に共通した遺伝的特徴を明らかに

2022年6月24日
特発性肺線維症の自動診断AIの共同開発に成功
2022年6月23日
4個の中性子だけでできた原子核を観測
2022年6月22日
1.3W高出力THz量子カスケードレーザーを実現
2022年6月22日
エタノールが植物の高温耐性を高めることを発見
2022年6月21日
リボソームタンパク質に起きる翻訳後修飾の機能
2022年6月21日
生細胞内のヒストンメチル化を追う
2022年6月18日
栄養が豊富過ぎると根毛は伸びなくなる
2022年6月17日
藻類の太陽光エネルギーを吸収する仕組みを解明
2022年6月16日
長鎖シークエンスにより網膜色素変性の原因遺伝子変異を解明
2022年6月14日
X線ライトシート顕微鏡
2022年6月14日
テラヘルツレーザーの室温発振を理論実証
2022年6月14日
生命現象を赤色光でコントロールする技術を開発
2022年6月13日
ヘリウム3原子核の磁石の強さ
2022年6月9日
脂肪前駆細胞の多様性を明らかに
2022年6月9日
治療薬開発に適したアルツハイマー病モデルマウスの開発
2022年6月7日
X線レーザーを照射された原子は遅れて動き始める
2022年6月6日
細胞が成長する過程におけるDNAの「ゆらぎ」をとらえた!
2022年6月3日
ペプチドとRNAの出会いが生命を生んだ?
2022年6月2日
炎症性腸疾患における漢方「大建中湯」の作用機構を解明
2022年6月1日
進化・生態ダイナミクスの共通法則
2022年5月30日
2次元結晶の積層構造由来の電気分極を反映した光起電力応答を発見
2022年5月26日
哺乳類最長の心臓再生可能期間を持つオポッサム
2022年5月26日
新型コロナウイルスの超高感度・全自動迅速検出装置の開発
2022年5月26日
全固体電池材料の真の姿をX線レーザーで観察
2022年5月26日
4億年前の謎の脊椎動物の正体解明
2022年5月25日
海藻養殖場の炭素固定能力の定量化に道を拓く成果
2022年5月24日
胃酸抑制剤の結合構造を解析
2022年5月24日
スピン情報損失を原子スケールで可視化
2022年5月23日
オジギソウ駆動型バルブ
2022年5月23日
磁場による超伝導電流増幅の機構を解明
2022年5月23日
酸素による表面反応経路の制御
2022年5月20日
清浄な架橋カーボンナノチューブに量子欠陥を導入
2022年5月20日
植物が病原菌特有の脂質を認識するしくみ
2022年5月19日
無精子症マウスから産子獲得に成功
2022年5月18日
B型肝炎ウイルス感染受容体であるヒト膜タンパク質の構造を解明
2022年5月18日
海洋細菌由来の新しいテルペン合成酵素の発見
2022年5月18日
炭素・窒素循環を担う昆虫共生細菌系の因果構造
2022年5月18日
B型肝炎ウイルスの受容体“胆汁酸輸送体”の立体構造を解明
2022年5月18日
可視光とX線の高速同時観測が明らかにした白色矮星をとりまく高温ガスの姿
2022年5月17日
シン・胸腺上皮細胞
2022年5月17日
小型中性子源で鋼材内部の応力の測定が可能に
2022年5月16日
カーボンナノチューブで植物に遺伝子を送り込む
2022年5月16日
SiO2ガラスの圧力下における異常特性の構造的起源
2022年5月13日
水を超高速で通すにもかかわらず塩を通さないフッ素ナノチューブを開発
2022年5月9日
鉱物が一瞬だけ衝撃を受けるとどうなるか
2022年5月9日
トンガ海底火山噴火のラム波を鮮明に可視化
2022年5月6日
巨視的な遷移における速度限界の発見
2022年5月6日
肝細胞発生過程で働く遺伝子スイッチ
2022年5月6日
タンパク質の選別輸送の品質管理
2022年5月1日
自閉症原因は胎児の時から?
2022年4月28日
元素起源の謎の解明に向けた世界最速質量測定が始動
2022年4月28日
母親ゲノムの記憶が胎児を育む
2022年4月27日
スーパーコンピュータ「富岳」で炭素の起源を探る
2022年4月27日
窒素がなくてもアミノ酸はできる!
2022年4月26日
多変数データを用いた非線形因果探索技術の開発
2022年4月26日
有限温度状態での量子もつれに関する普遍的性質の発見
2022年4月26日
暗黒の細胞死の発見
2022年4月26日
色褪せない蛍光タンパク質
2022年4月25日
次世代放射光実験中に生じるX線の輝度変動を大幅に低減
2022年4月25日
スパイクタンパク質の構造変化を予測
2022年4月22日
エネルギー分解型光モニターを開発
2022年4月20日
父親の子育てを支える神経回路の変化
2022年4月19日
高CO2条件での植物の成長促進に関連する遺伝子を発見
2022年4月18日
世界最強のポータブル磁場発生機を完成、77テスラで量子ビーム実験に成功
2022年4月15日
10万人以上を対象としたBRCA1/2遺伝子の14がん種を横断的解析
2022年4月14日
始原的なシアノバクテリアの光化学系I複合体の立体構造を解明
2022年4月13日
精子のエピゲノムは人それぞれ
2022年4月13日
らせん状のキラル分子は熱で磁石になる
2022年4月12日
アロステリック薬剤はタンパク質の構造平衡を変化させる
2022年4月11日
妊娠中の運動が子の肥満を防ぐ仕組みを解明
2022年4月11日
動物の形態進化は、「体づくり過程の変化しにくさ」に制限されてきた
2022年4月8日
窒素分子と二酸化炭素から有機物を合成
2022年4月5日
宇宙観測技術で分子イメージングの新技術を開発!
2022年4月4日
種子の油を合成する新しい代謝経路を発見

2022年4月1日
甲状腺の初期進化
2022年3月31日
結晶の対称性を反映した新しい原理の超伝導整流現象を発見
2022年3月31日
超高密度な磁気渦を示すシンプルな二元合金物質を発見
2022年3月31日
テラヘルツ光を電流へ変換する新原理の発見
2022年3月31日
光合成真核生物で初の光化学系I複合体の多量体構造を解明
2022年3月31日
単一分子光電流計測法の開発
2022年3月30日
脳の意識統合機構を解明
2022年3月29日
ヒトiPS細胞からの視細胞直接誘導法
2022年3月28日
制御シミュレーション実験
2022年3月28日
大強度加速器×超高精度“温度計”で原子核を作る力に迫る
2022年3月25日
好熱菌を黒毛和種仔牛に投与!
2022年3月25日
結晶中の強く相関する電子雲の振る舞いを解明
2022年3月25日
「100兆分の1秒」のX線レーザー時間幅を実測
2022年3月25日
自己免疫疾患の最大のリスク因子の機能を解明
2022年3月24日
世界最高出力のアト秒レーザー
2022年3月22日
説明可能AIを用いた超音波画像診断支援
2022年3月22日
脂質代謝の遺伝子回路を公開情報から再構築
2022年3月18日
植物の細胞分裂期の代謝物質を解明
2022年3月17日
量子の世界で群れを作る
2022年3月11日
農薬耐性イネいもち病菌の防除化合物
2022年3月10日
自然免疫に重要なKIR遺伝子領域の構造を解明
2022年3月10日
人工知能で蛍光有機分子を開発
2022年3月9日
常識を覆す糖の再排出メカニズムの発見
2022年3月7日
シミュレーションで線状降水帯の豪雨予測精度を改善
2022年3月4日
カビから見つけた抗マラリア化合物
2022年3月3日
光で誘電率を大幅に自在制御できる液晶性強誘電体
2022年3月3日
酵素の機能改変で自然界にないイソプレノイドを合成
2022年3月3日
アルツハイマー病病因分子の産生量に影響を与える土壌微生物叢由来代謝物の同定
2022年2月28日
電荷が反対の粒子間に斥力が働く状況を実現
2022年2月28日
光でイオンを輸送する膜タンパク質の巧妙な仕組み
2022年2月25日
いつでもどこでも血管内治療トレーニングが可能に
2022年2月23日
スプレーで植物を改変
2022年2月22日
細菌一つを見分ける細菌叢計測法の開発
2022年2月18日
iPSコホートと機械学習を用いたアルツハイマー病再構成
2022年2月18日
制御性T細胞の新しいマーカーを発見
2022年2月18日
アミロイドの脱凝集メカニズムを解明
2022年2月17日
昆虫ホルモンの生合成を撹乱する蚊の発育阻害剤の発見
2022年2月15日
ヒトの運動を支援するロボット
2022年2月15日
酸性環境で駆動する非貴金属水電解触媒
2022年2月14日
伝導電子と局在スピン・軌道が織りなす悪魔の調律
2022年2月11日
ルーフ配位子で位置選択的合成に成功
2022年2月10日
シグナル伝達の「偏り」を生み出すリン酸化機構の解明
2022年2月10日
ヒトのように表情をつくれるアンドロイドを開発
2022年2月9日
がん細胞のフェロトーシスを増強する化合物を発見
2022年2月9日
最適な根の長さとは
2022年2月8日
孤独を感じ仲間を求める脳内回路
2022年2月7日
計算機上で収集したデータの機械学習による不斉触媒設計
2022年2月7日
卵巣がんの新しい治療標的を同定
2022年2月4日
植物の地下での情報のやりとりを発見
2022年2月4日
原始内胚葉幹細胞の樹立に成功
2022年2月3日
金属硫化物を用いた二酸化炭素還元電極触媒の設計指針を提示
2022年1月28日
二次元ディラック電子の量子異常を実証
2022年1月25日
磁気異方性制御によるアンチスキルミオンの安定化に成功
2022年1月24日
オペロン構造の進化過程の実証実験に成功
2022年1月21日
シグナル伝達による多様な細胞応答の起源
2022年1月21日
機能性の高い移植用網膜組織の開発
2022年1月20日
シリコン量子ビットで高精度なユニバーサル操作を実現
2022年1月19日
ゲノム編集の結果を正しく理解する

2022年1月18日
胎盤らしさを支える分子基盤を解明
2022年1月17日
DPANN群に属する難培養性アーキアの培養に成功
2022年1月17日
カゴメ格子に由来する磁気熱電効果の増大機構の発見
2022年1月14日
神経回路は潜在的な統計学者
2022年1月14日
固体中電子の電磁応答の統一
2022年1月14日
B型肝炎ウイルス感染を抑制する抗体を開発
2022年1月10日
体内でベンゼン環を作る
2022年1月6日
量子もつれに劇的な変化をもたらす新たな条件の発見
2022年1月6日
植物で新奇な細胞内取り込み機構を誘起するペプチド
2022年1月6日
反物質と太陽の重力相互作用
2022年1月5日
腎がんの「ゲノム医療」に貢献
